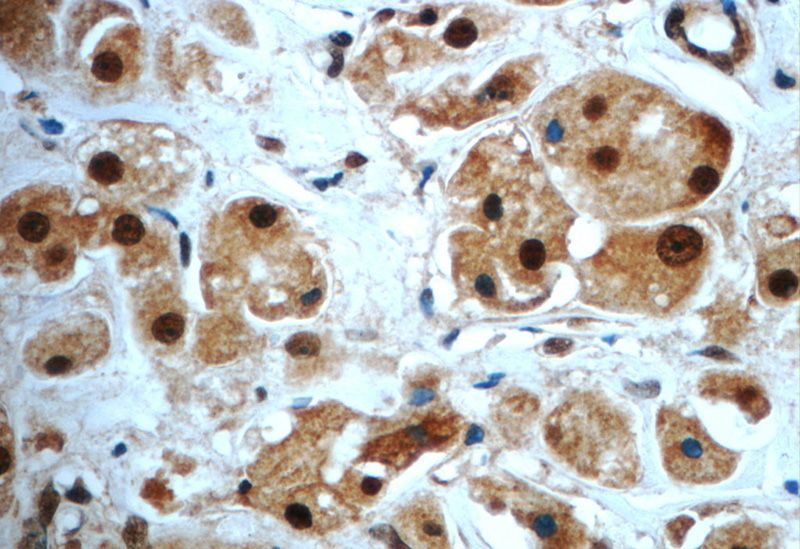
Immunohistochemistry of paraffin-embedded human breast cancer slide using Catalog No:115043(SAFB Antibody) at dilution of 1:50

-
Product Name
SAFB antibody
- Documents
-
Description
SAFB Rabbit Polyclonal antibody. Positive IF detected in A431 cells. Positive IHC detected in human breast cancer tissue, human testis tissue. Positive WB detected in MCF-7 cells, A431 cells, HEK-293 cells, HeLa cells, HepG2 cells, MCF7 cells. Observed molecular weight by Western-blot: 150 kDa
-
Tested applications
ELISA, WB, IF, IHC
-
Species reactivity
Human; other species not tested.
-
Alternative names
DKFZp779C1727 antibody; HAP antibody; HET antibody; HSP27 ERE TATA binding protein antibody; SAF B antibody; SAF B1 antibody; SAFB antibody; SAFB1 antibody; scaffold attachment factor B antibody; Scaffold attachment factor B1 antibody
-
Isotype
Rabbit IgG
-
Preparation
This antibody was obtained by immunization of SAFB recombinant protein (Accession Number: NM_001201338). Purification method: Antigen affinity purified.
-
Clonality
Polyclonal
-
Formulation
PBS with 0.02% sodium azide and 50% glycerol pH 7.3.
-
Storage instructions
Store at -20℃. DO NOT ALIQUOT
-
Applications
Recommended Dilution:
WB: 1:500-1:5000
IHC: 1:20-1:200
IF: 1:20-1:200
-
Validations

MCF-7 cells were subjected to SDS PAGE followed by western blot with Catalog No:115043(SAFB Antibody) at dilution of 1:1000
Immunohistochemistry of paraffin-embedded human breast cancer slide using Catalog No:115043(SAFB Antibody) at dilution of 1:50

Immunofluorescent analysis of A431 cells using Catalog No:115043(SAFB Antibody) at dilution of 1:50 and Alexa Fluor 488-congugated AffiniPure Goat Anti-Rabbit IgG(H+L)
-
Background
Heterogeneous nuclear ribonucleoproteins (hnRNPs) constitute a set of polypeptides that contribute to pre-mRNA processing and transport. hnRNPs also bind heterogeneous nuclear RNA (hnRNA), the transcripts produced by RNA polymerase II. SAFB (scaffold attachment factor B) is a nuclear matrix-associated protein that binds to matrix- or scaffold-associating regions (MARs or SARs) on DNA and interacts with RNA polymerase II and serine-/arginine-rich RNA processing factors (SR proteins). SAFB, also designated HAP (hnRNP A1 associated protein) and HET (HSP 27-ERE-TATA-binding protein) is a proven hnRNP protein that has a speckled distribution in the nucleus and, in response to stress agents such as heat shock, is recruited to a few, large nuclear granules, called perichromatin granules. SAFB also binds to the estrogen receptor (ER) and is expressed in several breast cancer cell lines at varying levels. Subsequently, SAFB may play a role in breast cancer by mediating cellular proliferation and division. This antibody specifically reacts whith the isoform 1 of human SAFB protein.
Related Products / Services
Please note: All products are "FOR RESEARCH USE ONLY AND ARE NOT INTENDED FOR DIAGNOSTIC OR THERAPEUTIC USE"
